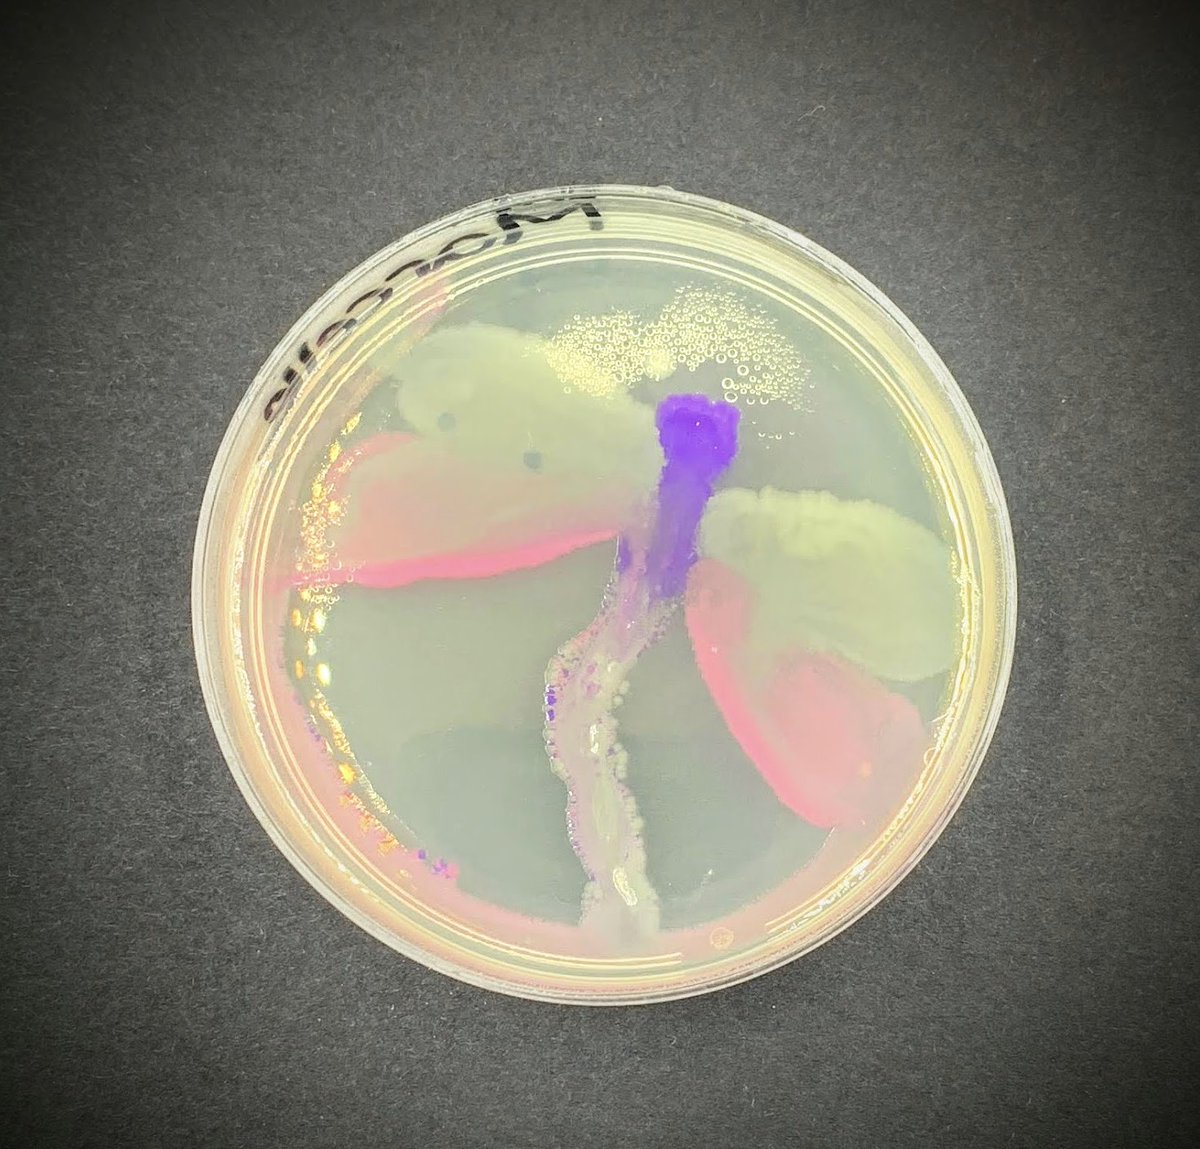
Aminobiolab's tweet image. The creations from the #agarart workshop at the Alberta Teacher Association Science Council Conference #ATASC2023 are ready! 🌟 Hats off to our talented #scienceteachers! 🙌 

📸 album: amino.bio/pages/atasc-20…  

@ATASciCouncil #STEM
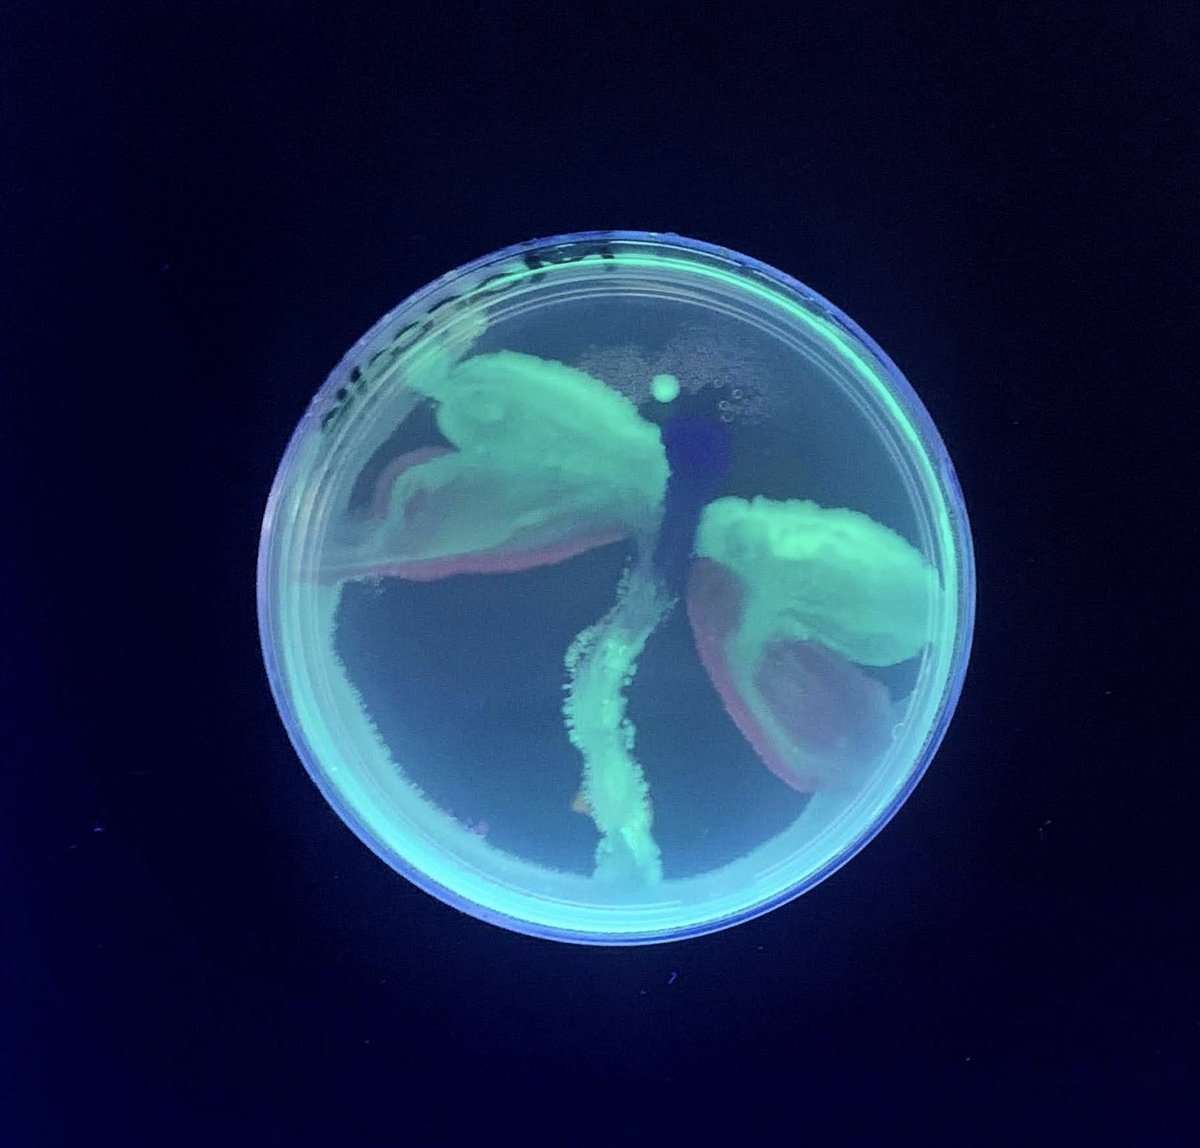
Aminobiolab's tweet image. The creations from the #agarart workshop at the Alberta Teacher Association Science Council Conference #ATASC2023 are ready! 🌟 Hats off to our talented #scienceteachers! 🙌 

📸 album: amino.bio/pages/atasc-20…  

@ATASciCouncil #STEM
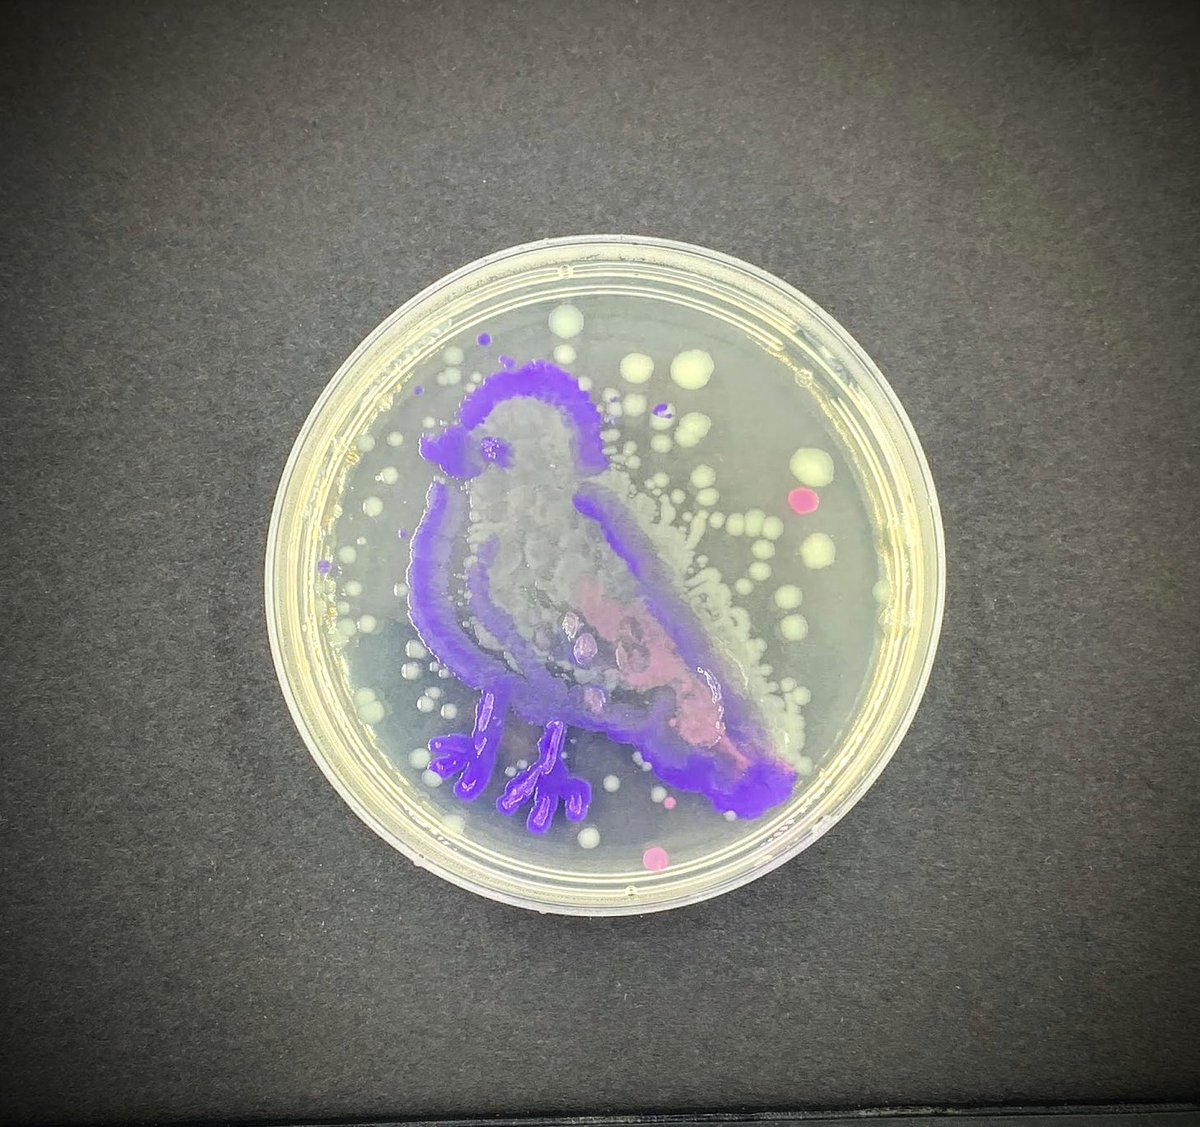
Aminobiolab's tweet image. The creations from the #agarart workshop at the Alberta Teacher Association Science Council Conference #ATASC2023 are ready! 🌟 Hats off to our talented #scienceteachers! 🙌 

📸 album: amino.bio/pages/atasc-20…  

@ATASciCouncil #STEM

#atasc2023 search results
Exciting to hear @CaulfieldTim share about misinformation to “our people”. @ATASciCouncil #atasc2023 #science

The after, and still the best of friends. @hotonesgameshow @riskindan @SciGeekJulie @ATASciCouncil #atasc2023

The truth is out there… For the next couple of days just call us Mulder & Scully ❤️ @MmeAmandaGreen @ATASciCouncil #atasc2023

When you get to share your spark for #science with your Science Teacher Soulmate it’s a great day! @SciGeekJulie @ATASciCouncil #atasc2023 @ata_pd @ATAlocal8

#BrucetheChowPup really teaches one about scale at #ATASC2023. This dog is about 10x bigger than what I envisioned from pictures. He's huge! The reality is that I really should have brought my two tiny dogs to make him look that much bigger! His size in this Pic makes sense!

Our @hotonesgameshow challenge is off! Let’s see how many @ATASciCouncil peeps make it through and that our special guest @riskindan and host @SciGeekJulie show them how it’s done! #atasc2023

Science is chipping away at incorrect hypotheses until you uncover the legitimate evidence. @riskindan kicking off the @ATASciCouncil conference this morning! Love! #atasc2023

And now for @riskindan’s better half - so excited to hear Dr. Shelby Riskin discuss climate change & biodiversity loss. @ATASciCouncil #atasc2023

Oh the memories! It's been a week since #ATASC2023! Mark it on your calendar and save the date! #ATASC2024 will be November 7-8-9, 2024. We will be back at Coast Canmore. If you thought 2023 was amazing bring extra socks cause we are going to blow them off in 2024 🤯 @ata_pd
Did you plan your #ATASC2023 sessions yet? #ScienceIsForEverybody #ScienceCommunication #ATASC #ATASciCouncil

Just getting ready for our special guests! #ATASC2023 #BrucetheChowPup @riskindan @CaulfieldTim #ATASC #ScienceCommunication

Look who's getting excited for #ATASC2023! #ATASciCouncil #ScienceCommunication #ScienceConference #ATASC #ScienceTeachers @ata_pd

#ATASC2023 delegates! Check your email for your link to make your SCHED schedule for conference! We have 20 spots for our Science of Capsaicin Hot Sauce Challenge with @SciGeekJulie at the Friday reception. (Check your spam folder if the email is not in your inbox) #ATASC


Thank you so much for your interest in #ATASC2023 Registration is now CLOSED as we are FULL We look forward to seeing delegates @CoastCanmore in 3 weeks. By the way, we have backpack SWAG for everyone who registered so you can thank the #SciencePups for making the swag order!


Join @SciGeekJulie at #ATASC2023 to sample 10 increasingly hotter sauces during our Friday Reception. Sign up on SCHED, only 13 spots still available. #ScienceIsForEverybody #ScienceCommunication #HotSauce #ATASC #ATASciCouncil #Capsaicin
Oh the memories! It's been a week since #ATASC2023! Mark it on your calendar and save the date! #ATASC2024 will be November 7-8-9, 2024. We will be back at Coast Canmore. If you thought 2023 was amazing bring extra socks cause we are going to blow them off in 2024 🤯 @ata_pd
The creations from the #agarart workshop at the Alberta Teacher Association Science Council Conference #ATASC2023 are ready! 🌟 Hats off to our talented #scienceteachers! 🙌 📸 album: amino.bio/pages/atasc-20… @ATASciCouncil #STEM




Check out this video from @MmeAmandaGreen for a summary of what happened at the Science of Capsaicin Hot Sauce Challenge #ATASC2023 #ScienceIsForEverybody @riskindan #HotSauce #ATASC instagram.com/reel/CzSjlpKLv…
Check out all of the fun had at #ATASC2023 with our #Science #teacher family! Thanks @riskindan and @CaulfieldTim for the inspiration! Also happy friendiversary @SciGeekJulie ! @ATASciCouncil vm.tiktok.com/ZMjWhdNXw/
Can't believe it's over @ATASciCouncil 😄 What an amazing few days hanging out with these amazing science nerds ❤️ 💕 #scicomm #sciencecommunication #atasc2023




Exciting to hear @CaulfieldTim share about misinformation to “our people”. @ATASciCouncil #atasc2023 #science

When you get to share your spark for #science with your Science Teacher Soulmate it’s a great day! @SciGeekJulie @ATASciCouncil #atasc2023 @ata_pd @ATAlocal8

The after, and still the best of friends. @hotonesgameshow @riskindan @SciGeekJulie @ATASciCouncil #atasc2023

Our @hotonesgameshow challenge is off! Let’s see how many @ATASciCouncil peeps make it through and that our special guest @riskindan and host @SciGeekJulie show them how it’s done! #atasc2023

And now for @riskindan’s better half - so excited to hear Dr. Shelby Riskin discuss climate change & biodiversity loss. @ATASciCouncil #atasc2023

Hey #ATASC2023 teachers! Stop by our table and find out about our amazing free AB curriculum-based resources! Project AG focuses on the diversity of ag, sustainability, tech and much more! #ATASciCouncil #abed #abteachers #projectagricultureab #freeteachingresources

Science is chipping away at incorrect hypotheses until you uncover the legitimate evidence. @riskindan kicking off the @ATASciCouncil conference this morning! Love! #atasc2023

Good morning #ATASC2023! We can't wait to see everyone later this afternoon - mark your schedules for 2:15 pm and come see our Braeden and Kat as we walk through teaching and learning about the Energy Transition. Great fun, practical ideas and all sorts of great resources!

#BrucetheChowPup really teaches one about scale at #ATASC2023. This dog is about 10x bigger than what I envisioned from pictures. He's huge! The reality is that I really should have brought my two tiny dogs to make him look that much bigger! His size in this Pic makes sense!

The truth is out there… For the next couple of days just call us Mulder & Scully ❤️ @MmeAmandaGreen @ATASciCouncil #atasc2023

Teaching critical thinking essential in our fight against misinformtion. My take: Teach kids about misinformation macleans.ca/society/misinf… via @macleans REALLY looking forward to speaking at @ATASciCouncil's #ATASC2023 event! Key community!🙏 #GoTeam #GoScience!
The after, and still the best of friends. @hotonesgameshow @riskindan @SciGeekJulie @ATASciCouncil #atasc2023

When you get to share your spark for #science with your Science Teacher Soulmate it’s a great day! @SciGeekJulie @ATASciCouncil #atasc2023 @ata_pd @ATAlocal8

Exciting to hear @CaulfieldTim share about misinformation to “our people”. @ATASciCouncil #atasc2023 #science

Hey #ATASC2023 teachers! Stop by our table and find out about our amazing free AB curriculum-based resources! Project AG focuses on the diversity of ag, sustainability, tech and much more! #ATASciCouncil #abed #abteachers #projectagricultureab #freeteachingresources

Our @hotonesgameshow challenge is off! Let’s see how many @ATASciCouncil peeps make it through and that our special guest @riskindan and host @SciGeekJulie show them how it’s done! #atasc2023

#BrucetheChowPup really teaches one about scale at #ATASC2023. This dog is about 10x bigger than what I envisioned from pictures. He's huge! The reality is that I really should have brought my two tiny dogs to make him look that much bigger! His size in this Pic makes sense!

Are you going to be at #ATASC2023 this week? Plan to stop at our display & chat with us! We have amazing resources for Alberta elementary, junior & senior high #science curriculum…all FREE! #ATASciCouncil #abed #abteachers #projectagricultureab #freeteachingresources

Look who's getting excited for #ATASC2023! #ATASciCouncil #ScienceCommunication #ScienceConference #ATASC #ScienceTeachers @ata_pd

Just getting ready for our special guests! #ATASC2023 #BrucetheChowPup @riskindan @CaulfieldTim #ATASC #ScienceCommunication

Did you plan your #ATASC2023 sessions yet? #ScienceIsForEverybody #ScienceCommunication #ATASC #ATASciCouncil

The creations from the #agarart workshop at the Alberta Teacher Association Science Council Conference #ATASC2023 are ready! 🌟 Hats off to our talented #scienceteachers! 🙌 📸 album: amino.bio/pages/atasc-20… @ATASciCouncil #STEM

Thank you so much for your interest in #ATASC2023 Registration is now CLOSED as we are FULL We look forward to seeing delegates @CoastCanmore in 3 weeks. By the way, we have backpack SWAG for everyone who registered so you can thank the #SciencePups for making the swag order!


Only 3 more sleeps until Thursday Registration and Reception at Coast Canmore for #ATASC2023!!! #ScienceIsForEverybody #ScienceCommunication #ATASC #ATASciCouncil @ata_pd

#ATASC2023 Delegates! Just a few rooms are available in this additional room block - book now! @ata_pd @albertateachers #Science #ScienceCommunication #ATASC #ATASciCouncil

#ATASC2023 delegates! Check your email for your link to make your SCHED schedule for conference! We have 20 spots for our Science of Capsaicin Hot Sauce Challenge with @SciGeekJulie at the Friday reception. (Check your spam folder if the email is not in your inbox) #ATASC


The #SciencePups are packed and ready for their road trip. Safe travels to Canmore #ATASC2023 Delegates! See You Soon! #ATASC #BrucetheChowPup #ScienceCommunication #ScienceConference #ATASciCouncil @ata_pd

Something went wrong.
Something went wrong.
United States Trends
- 1. Araujo 174K posts
- 2. Chelsea 601K posts
- 3. Barca 241K posts
- 4. Estevao 237K posts
- 5. Ferran 75K posts
- 6. Barcelona 431K posts
- 7. Yamal 183K posts
- 8. Oklahoma State 4,333 posts
- 9. Eric Morris 2,832 posts
- 10. Cucurella 92.6K posts
- 11. Flick 45.3K posts
- 12. Rashford 23.8K posts
- 13. Godzilla 24.6K posts
- 14. Kounde 46.9K posts
- 15. Pedri 51.3K posts
- 16. Enzo 64.1K posts
- 17. #CHEBAR 16.3K posts
- 18. Skippy 4,223 posts
- 19. Raising Arizona 1,665 posts
- 20. Happy Thanksgiving 24.5K posts














